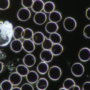

ZADIHAJTE ŽIVLJENJE
Naši programi so osredotočeni na

Pospeševanje
regeneracije

Dvig kolagena
in glajenje gub

Sijoč izgled
kože in las
Naši programi so osredotočeni na

Pospeševanje regeneracije

Dvig kolagena in glajenje gub

Sijoč izgled kože in las

HBOT komora
Hiperbarični kisikov tretma (HBOT) je postopek, pri katerem dihamo čisti kisik v komori s povišanim atmosferskim tlakom, da izboljšamo naravne zdravilne moči našega telesa. Tretma je povsem naraven in se izvaja tako, da klienta izpostavimo tlaku, ki je višji od atmosferskega ter ga oskrbimo s čistim kisikom preko posebne naprave, imenovane hiperbarična komora.
TEST VITALNOSTI KISIKON™
Priporočamo, da opravite TEST VITALNOSTI KISIKON™, ki ga opravljamo v našem centru.
Test Vitalnosti nam omogoča, da sestavimo vašemu organizmu prilagojen paket z odvzemom kapljice krvi in pregled živih celic v krvi.


TEST VITALNOSTI KISIKON™
Priporočamo, da opravite TEST VITALNOSTI KISIKON™, ki ga opravljamo v našem centru.
Test Vitalnosti nam omogoča, da sestavimo vašemu organizmu prilagojen paket z odvzemom kapljice krvi in pregled živih celic v krvi.

KRIO komora
S pomočjo tekočega dušika s temperaturo -195°C ohlaja zrak, ki se vpihuje v krio komoro. Čas trajanja terapije je 2 – 3 min. Krioterapija celotnega telesa aktivira v možganih proces sproščanja adrenalina in endorfinov v krvni obtok, zaradi česa boste zaznali občutek sreče in okrepitve.
Skrivnost ne leži v napravah, ampak je zaklenjena™ v skrbno pripravljenih postopkih seans.
Skrivnost ne leži v napravah, ampak je zaklenjena™ v skrbno pripravljenih postopkih seans.
Kaj morate vedete pred KISIKON™ seansami?
Priprava
Pred seanso je priporočljivo zaužiti lahek obrok, saj boste zaradi izgorevanja kalorij lahko občutili lakoto. Če jemljete kakšna zdravila, o tem obvestite operaterja. To je pomembno, ker lahko nekatera zdravila spremenijo odziv vašega telesa na kisik. Če imate srčni spodbujevalnik, o tem obvestite operaterja. Nekateri ljudje z določenimi srčnimi spodbujevalniki zaradi tega namreč ne smejo uporabljati HBOT in Krio seans.
Pred seanso
Prosili vas bomo, da se preoblečete v oblačila, ki jih dobite pri operaterju; Pred vstopom v komore priporočamo obisk toaletnih prostorov. Naslednjih predmetov iz varnostnih razlogov ne smete nositi v komore:
vžigalnike ali vžigalice;
ličila, šminke, mazila za ustnice;
lak za lase, olje za lase;
parfum, voda po britju, kolonjska voda;
lasulje, lasni vložki;
krema za roke ali telo, mazila;
lak za noht;
umetne trepalnice;
najlonske nogavice;
ure in nakit;
slušni aparati;
sintetična oblačila;
kontaktne leče;
flomastri;
elektronska oprema, vključno z mobilnimi telefoni;
Pomembno je upoštevati varnostne ukrepe, saj se med seansami uporablja močno obogaten kisik. Ne glede na pozitivne učinke, ki jih ponujajo regeneracijske seanse, kljub vsemu obstajajo tudi omejitve.
HBOT komora
V komoro ne sprejemamo vinjenih strank, strank pod vplivom opojnih substanc oziroma strank z diagnozami neprimernimi za storitve, ki jih izvaja naš center.
Vsem strankam z diagnozami priporočamo predhodni posvet z ličečim zdravnikom oziroma specialistom hiperbarične medicine. Slednji posvet lahko naročite v našem centru.
V komoro ne sprejemamo otrok mlajših od 12 let.
KRIO komora
V KRIO komoro ne sprejemamo strank:
– ki so v slabem zdravstvenem stanju;
– se spopadajo s kroničnim obolenjem srca in ožilja;
– so preboleli infarkt;
– imajo težave s previsokim krvnim tlakom,
– imajo vročino;
– so mlajše od 10. leta starosti;
– so bodoče mamice.
Prihod v regeneracijski center in potek seans
HBOT komora
V regeneracijskem centru vas pričakujemo 15 minut pred seanso, prvič pa, zaradi vpisa v sistem, 20 minut pred seanso; Vaš obisk v Kisikonu ™ traja približno uro in pol od prihoda do odhoda; Pred, med in po seansi vas naprošamo, da sledite navodilom operaterja.
KRIO komora
V regeneracijskem centru vas pričakujemo 15 minut pred seanso, prvič pa, zaradi vpisa v sistem, 20 minut pred seanso; V kolikor ste naročeni le na krio seanso, bo vaš obisk trajal od 15-20 minut, Krio seansa pa od 2 do 3 minute; Pred, med in po seansi vas naprošamo, da sledite navodilom operaterja.
ZAGOTOVITE SI TERMIN